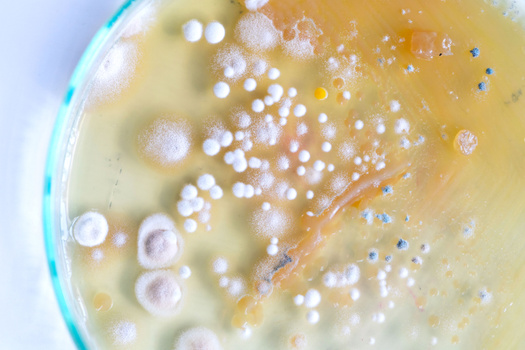

«Кажется, бактерии побеждают науку» Ученый Павел Певзнер, создающий инструменты для поиска новых антибиотиков, — об эпидемиях, которые грозят человечеству в середине столетия
Мы рассказываем честно не только про войну. Скачайте приложение.
Международная группа ученых по заказу премьер-министра Великобритании провела исследование болезнетворных бактерий, устойчивых к антибиотикам. Из него следует, что к 2050 году эти бактерии могут убивать до 10 миллионов человек в год. Уже сейчас от них умирают как минимум десятки тысяч людей. Найти новые антибиотики очень сложно, но ученые по всему миру пытаются это сделать. Один из них — биоинформатик Павел Певзнер, петербургская лаборатория которого разработала уже несколько инструментов для поиска новых эффективных антибиотиков. «Медуза» поговорила с Певзнером об угрозе новых эпидемий, разнице в развитии науки в России и США — и о том, почему математики и информатики все больше нужны для развития биологии.
— Как вы начали заниматься наукой?
— В школе я очень плохо учился до четвертого класса, а потом резко стал отличником — папа пообещал, что мы заведем собаку, если я это сделаю. Но, видимо, он не верил, что это возможно, и собаку мы так и не завели.
После этого я продолжал хорошо учиться — увлекался математикой, выигрывал олимпиады. Потом переехал в Москву, где жил и учился в школе-интернате для одаренных детей при МГУ. Но в итоге окончил [Московский] институт инженеров железнодорожного транспорта. Этот институт был специальным местом в Москве для тех, кто не поступил в МГУ.
— Как появилась идея заняться биоинформатикой?
— Я отучился, а потом около пяти лет занимался решением математических проблем железнодорожного транспорта. В какой-то момент мне стало так скучно возиться с транспортом, что я начал рассматривать другие области. Серьезно раздумывал заняться проблемой прогнозирования землетрясения. Очень рад, что не пошел в эту сторону, потому что [эффективно] землетрясения до сих пор прогнозировать так никто и не научился.
Такой дисциплины, как биоинформатика тогда формально не существовало, но по факту она уже была. Поэтому я посмотрел в сторону генетики, там были очень интересные задачи. В конце 1980-х ученые уже даже умели расшифровывать геномы вирусов, и в «ГосНИИгенетике» я занимался задачами, связанными с этим.
Сейчас из расшифровки генома выросла целая многомиллиардная индустрия — и нужно понимать, что это произошло именно из-за биоинформатиков. Многие думают, что для расшифровки нужны биологи, но на самом деле это не так. Это задача, скорее, для математиков и специалистов в computer science.
Биоинформатика сейчас — одна из самых популярных и развивающихся наук. Если раньше среди биологов биоинформатиков практически не было, то сейчас их количество достигает процентов 30. Биологию и персональную медицину уже нельзя представить без биоинформатики.
— Вы начинали карьеру в конце 80-х. Как тогда выглядело советское НИИ с точки зрения условий работы?
— Было очень много талантливых специалистов. Но если вы говорите про материальные условия, зарплаты, то их почти не было. Правда, у меня небольшие потребности, поэтому было нормально.
Компьютеры тоже были не самыми продвинутыми, но так как я занимаюсь алгоритмами, то для меня это было не так страшно. Хороший алгоритм на старой «машине» будет работать быстрее, чем плохой на новом компьютере.
— Почему же в 1990 году вы уехали в США?
— Потому что там находится передний край науки.
— Как вы уехали?
— Довольно забавная история. Советские ученые тогда практически не публиковались в западных журналах, а через интернет связаться ни с кем было нельзя — его еще не было. Но можно было послать кому-нибудь из западных ученых такое «письмо-открытку». Я отправил его Майклу Ватерману, который считается одним из отцов биоинформатики, и попросил его прислать мне какую-нибудь его статью.
Он неожиданно ответил и прислал целый пакет статей, в том числе еще неопубликованные. Я их посмотрел, увидел одну нерешенную проблему и написал, как ее, по моему мнению, можно было бы решить. Написал об этом Майклу, а он в ответ пригласил меня приехать в США на конференцию. Я приехал, а затем Майкл уже пригласил меня в свою лабораторию в качестве постдока.
Как я потом выяснил, Майкл получил мое письмо с решением, но, так как у меня тогда был ужасный английский, он ничего не понял. Но все равно решил позвать меня.
— Тогда не было проблем, чтобы уехать из СССР?
— Каких-то серьезных трудностей с этим я не помню. Сложности были другие. Очень хорошо помню, как мы с женой прилетели в Лос-Анджелес с 300 долларами в кармане. Это очень маленькая сумма и первое время было тяжело. Но накопить хотя бы тысячу долларов советскому ученому в те годы было сложно.
— Для сравнения — какая у вас была первая зарплата в США?
— 32 тысячи [долларов] в год.
— Ваши ожидания от науки в США оправдались?
— Да. Задачи были самые современные и интересные. Кроме того, было очень полезно научиться выбирать самые важные из этих задач. Например, в России и сейчас многие ученые сидят в своей лаборатории, занимаются очень узкой темой и не понимают, что до нее в мире никому нет дела.
— В США вы сделали карьеру, а потом вас пригласили в Сингапур, который очень быстро стал одним из мировых центров по биоинформатике. Как им это удалось?
— Да, меня пригласили в консультативный научный совет Института генома. В Сингапуре все получилось по целому комплексу причин. Во-первых, потому что какое-то количество времени назад они вложили очень много денег в развитие науки. Но одних ресурсов недостаточно. Нужно сделать еще несколько шагов: переманить «звезд», а потом убедить людей, что за ними можно поехать. Сингапуру это удалось. Они предлагали людям зарплату выше рынка и убеждали, что им там будет комфортно жить.
Когда в Сингапуре все только начиналось, один из моих учеников получил предложение оттуда. При этом у него были хорошие варианты и в США. Я говорил ему, что лучше остаться, но он уехал и сделал там отличную карьеру. Сейчас я уже отговаривать никого не буду.

— В России такого роста пока нет. И вы как-то сказали, что по сравнению с США мы — провинция с точки зрения науки. Говорили, что мнение о том, что в России живут лучшие программисты или биологи сродни вере в то, что «лучшие портные живут в Жмеринке».
— Я говорил это лет семь назад и с тех пор многое изменилось — появляются новые лаборатории и так далее. В первую очередь это происходит, конечно, из-за усилий правительства и финансирования.
— Но мы все еще провинция?
— Как посмотреть. В России есть лаборатории и ученые, которые работают на мировом уровне. Например, Михаил Гельфанд или Дмитрий Чудаков. Но проблема в том, что таких ученых мало и они есть далеко не во всех областях. Простой пример: в одном моем университете в Сан-Диего профессоров-экспертов по биоинформатике больше, чем во всей России. Это может показаться странным, но это так.
— При этом у вас есть своя лаборатория в России, в Петербурге. Как это вышло?
— Дело в том, что в США у профессоров есть такое понятие как «сабатикл». Раз в несколько лет я могу взять оплачиваемый отпуск на год и заниматься тем, чем захочется. Я практически никогда не пользовался этой возможностью, но к 2011 году подумал, что можно взять такой отпуск. Сначала мы с женой думали поехать в Швейцарию — были хорошие предложения. Но потом появился вариант с Россией по мегагранту. Мне было интересно вернуться в Россию, так как знаю, что в стране много талантливых людей.
Я открыл лабораторию биоинформатики в Академическом университете, но никаких биоинформатиков тогда в Петербурге еще не было. Мы приглашали студентов или свежих выпускников — программистов, людей из computer science и так далее.
Занялись сразу несколькими направлениями. Много работали над геномным сборщиком. Это специальная программа, позволяющая из разрозненных кусочков генома (сейчас ученые считывают геном по частям — прим. «Медузы»), как из деталей пазла, собрать его исходную последовательность или, по крайней мере, получить достаточно большие фрагменты, с которыми уже можно дальше работать. Это очень нужная базовая вещь для работы.
Сейчас наш геномный сборщик — один из самых популярных в мире. Он называется SPAdes (St. Petersburg genome assembler). Статья про этот сборщик, опубликованная семь лет назад, быстро стала самой цитируемой статьей российских ученых за последнее десятилетие — у нее уже почти семь тысяч ссылок.
Через пару лет работы в Академическом университете лаборатория переехала в Санкт-Петербургский государственный университет. Дело в том, что мегагрант через год закончился и начались проблемы с финансированием. Сейчас нас полностью поддерживает СПбГУ.
— Одно из главных направлений в вашей российской лаборатории — разработка инструментов для поиска новых антибиотиков. Как вы считаете, насколько серьезна угроза устойчивости бактерий?
— Очень серьезна. Это глобальная проблема, которая касается всех стран. Дело в том, что когда мы применяем антибиотик, может сложиться ситуация, при которой 99,9% бактерий погибает, а 0,1% выживает и становится устойчивым к этому антибиотику. Так постепенно появляются бактерии-монстры, устойчивые сразу к нескольким антибиотикам. Их очень сложно победить.
По факту сейчас мы находимся в ситуации, когда люди умирают от тех болезней, которые мы уже давно, казалось бы, победили. Но теперь они вернулись и средств борьбы против них нет. Также есть опасность появления новых заболеваний, против которых у нас тоже может не оказаться лекарств.
— Почему сложилась такая ситуация?
— Есть проблема с бесконтрольным использованием антибиотиков. Антибиотики часто применяют для борьбы с заболеваниями, которые ими вообще не лечатся. Или бросают их пить как только состояние немного улучшается. Все это чревато тем, что некоторые болезнетворные бактерии выживут и станут устойчивы.
Но еще важнее то, что антибиотики широко и часто бесконтрольно применяют в сельском хозяйстве (из-за использования лекарства у бактерий появляется возможность приспособиться к такому антибиотику, а затем заразить человека или передать этот ген устойчивости другим бактериям, которые способны вызвать инфекции у людей, — прим. «Медузы»).
Это должно решаться строгим контролем за оборотом антибиотиков, но пока мы находимся в сложной ситуации.
— А новые антибиотики найти сложно?
— Да. Проблема в том, что к середине 1990-х люди открыли все антибиотики, которые было легко найти. После этого много лет не получалось найти ни одного принципиально нового антибиотика, пока в 2015 году не открыли теиксобактин, который, скорее всего, является антибиотиком нового класса. Сейчас это основной претендент на такое звание. Он проходит клинические испытания, но нужно понимать, что выход нового антибиотика на рынок занимает порядка 10 лет с момента его открытия.
Проблем в поиске новых антибиотиков очень много. На самом деле, есть вероятность, что новый антибиотик можно найти, внимательно исследовав ваш письменный стол. Или изучив почву в ближайшем парке. Но сложность в том, что далеко не все бактерии мы умеем культивировать в лаборатории.
Еще есть проблема траты ресурсов. Например, вы взяли образцы почвы, принесли их в лабораторию и даже обнаружили, что в ней есть какие-то действующие вещества. Потратили силы на их изучение, но в итоге выясняется: все, что вы изучали, уже давно было кем-то открыто и изучено. И вам приходится начинать все с начала.
Мы в лаборатории разработали метод VarQuest, который решает эту проблему. Дело в том, что международное научное сообщество накопило огромные объемы масс-спектров, полученных из бактерий со всего мира — например, из океана, который сейчас считается очень перспективной для изучения средой. Среди этих данных наверняка есть много антибиотиков, но обнаружить их не получается просто из-за большого объема данных.
Наш метод позволяет обрабатывать масс-спектры автоматически и отсеивать уже обнаруженные антибиотики и их модификации. Так ученые могут сконцентрироваться только на том, что действительно стоит изучить. Кроме того, мы уже разработали еще одну программу, которая будет искать именно новые антибиотики. Но публикаций о ней мы еще не делали.
— Антибиотики производят бактерии, но почему мы до сих пор ищем их в природе, например, в океане, как вы сказали? Почему просто не синтезируем в лаборатории?
— Во-первых, в природе еще много не открытых нами антибиотиков. Во-вторых, часто непонятно, как именно их синтезировать: что конкретно менять в уже имеющихся антибиотиках, как менять и так далее.
— Говорят о том, что вместо антибиотиков можно использовать вирусы, которые заражают и убивают бактерии, — бактериофаги. Стоит ли надеяться на это, если с новыми антибиотиками ничего не получится?
— Да, фаговая терапия существует. Но мы очень мало знаем об этой теме. По фаговой терапии мы сейчас находимся в точке, примерно соответствующей 1930-40-м годам по антибиотикам. О массовом применении сейчас очень рано говорить. И непонятно, когда мы дойдем до этого.
— Как вообще выглядит проблема с антибиотиками изнутри? Сейчас это гонка науки и бактерий на выживание?
— Это всегда было устроено, как гонка. Ученые находят антибиотик, а бактерии потом приспосабливаются к нему. Потом мы находим еще один антибиотик и все повторяется. Другое дело, что прямо сейчас, кажется, бактерии побеждают науку.
— Что тогда будет дальше? Нас ждет эпидемия?
— Смотрите, только в США метициллин-резистентная разновидность золотистого стафилококка сейчас уносит жизни около 20 тысяч человек в год. И из-за устойчивости бактерии врачи не могут ничего с этим сделать. Наверно, это нельзя назвать эпидемией, но ситуация очень серьезная.
По поводу будущего есть самые разные оценки. Есть пессимистичный прогноз, что к 2050 году подобные бактерии будут убивать 10 миллионов человек в год. Но я верю в лучшее. Думаю, наука справится. Правда, есть важная проблема — крупные фармацевтические компании не так просто заинтересовать возможностью разработать новый антибиотик.
— Почему? Результата почти нет, а затраты растут?
— Все просто. Допустим, вы сделали антибиотик. Пусть он даже стоит тысячу долларов, но человек его выпьет один раз и все. А средство против головной боли человек будет пить каждый день годами. Причем разработать его и вывести на рынок гораздо проще и дешевле, чем антибиотик.
— Наверное, в это должны вмешаться государства?
— Они работают над проблемой, но правда в том, что государственной структуры, которая может самостоятельно разработать и вывести на рынок новый антибиотик, сейчас нет нигде. Надеюсь, это изменится.
Павел Мерзликин
(1) Биоинформатика
Совокупность методов из математики, статистики и информатики, которые применяются для решений задач в генетике, фармакологии и биологии.
(2) Постдок
Временная позиция (ставка) в зарубежных вузах и научно-исследовательских учреждениях, которую занимают молодые ученые со степенью.
(3) Михаил Гельфанд
Российский биоинформатик, один из основателей сообщества «Диссернет», проверяющего диссертации на плагиат. Занимается сравнительной геномикой и другими дисциплинами.
(4) Дмитрий Чудаков
Российский биолог. Наиболее известен как разработчик генетически кодируемых флуоресцентных маркеров для визуализации объектов и процессов в биомедицинских исследованиях. Один из ведущих мировых специалистов в этой области.
(5) Мегагранты
Открытый конкурс правительства России для привлечения ведущих мировых ученых в российские вузы с помощью грантов размером до 150 миллионов рублей. Проводится с 2010 года. Система была признана успешной — она позволила привлечь в вузы нобелевских лауреатов и других именитых ученых, было создано больше 200 лабораторий.
(6) SPAdes
Геномный ассемблер, разработанный в Петербурге, позволяющий собирать считанные кусочки ДНК в единую конструкцию. Применяется по всему миру для исследования бактерий, которые необходимы в том числе для создания новых медицинских препаратов. Создатели заявляли, что он может также использоваться в ДНК-анализе в криминалистике.
(7) Подробней
О непредсказуемых последствиях незаконченного курса антибиотиков можно прочитать в этом материале «Медузы».
(8) Масс-спектрометрия
Метод исследования и идентификации веществ по отношению масса к заряду ионов.